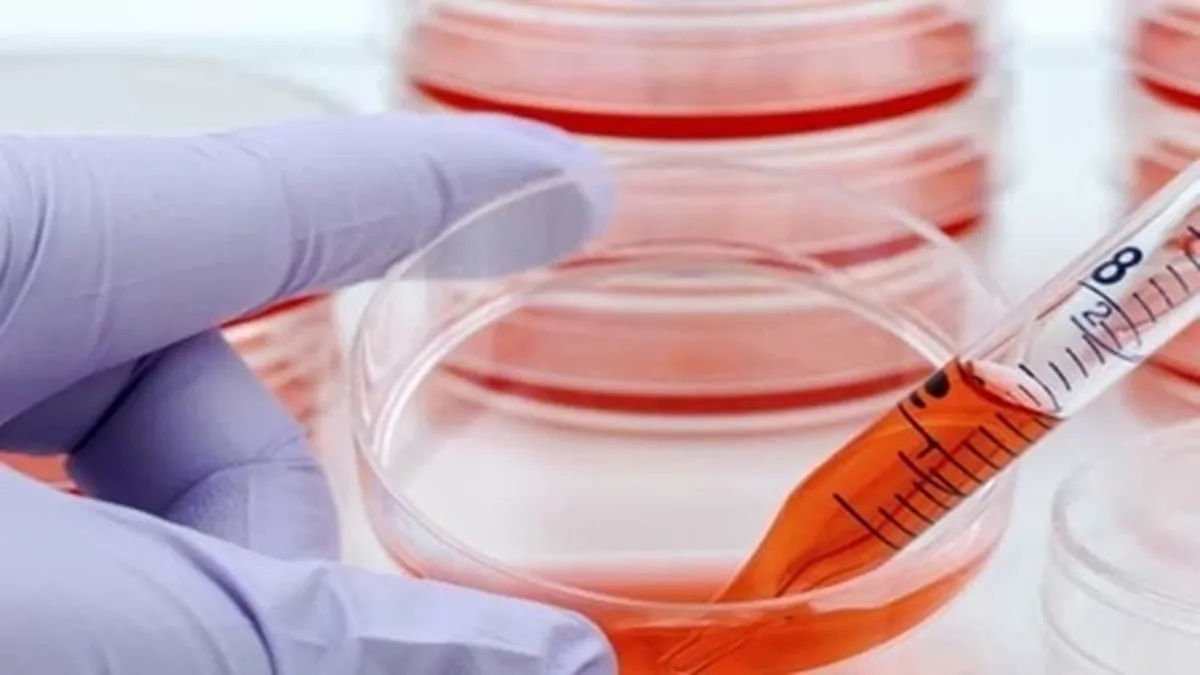

مراکز سلولدرمانی و صادرات تجهیزات سلولدرمانی در کشورهای همسایه راهاندازی میشود
به گزارش خبرگزاری علم و فناوری آنا،امیرعلی حمیدیه دبیر ستاد توسعه علوم و فناوریهای سلولهای بنیادی معاونت علمی، فناوری و اقتصاد دانش بنیان ریاست جمهوری از تلاشهای وزارت امورخارجه و این ستاد درخصوص ارتباط موثر با کشورهای منطقه درحوزه سلولهای بنیادی و پزشکی بازساختی خبر داد.
حمیدیه در جلسهای مشترک با تعدادی از سفرای ایران در چند کشور و جمعی از مدیران عامل شرکتهای حوزه سلولهای بنیادی و پزشکی بازساختی که در محل وزارت امور خارجه برگزار شد تاکید کرد: حمایت از توسعه و انتقال فناوریهای حوزه سلولهای بنیادی و پزشکی بازساختی و تعامل با کشورهای هدف جهت ایجاد فرصت توسعه همکاریهای مشترک آموزشی و پژوهشی ایران و دیگر کشورها باید افزایش یابد.
دبیر ستاد توسعه علوم و فناوریهای سلولهای بنیادی معاونت علمی همچنین ادامه داد: تلاشها و پیگیریهای وزارت امور خارجه زمینهساز ارتباط مؤثر با کشورهای منطقه است و ستاد توسعه علوم و فناوریهای سلولهای بنیادی نیز سعی دارد تا در راستای توسعه همکاریهای بینالمللی موضوع انتقال فناوری، آموزش و توانمندسازی پزشکان و راهاندازی مراکز سلول درمانی و صادرات تجهیزات سلول درمانی در کشورهای همسایه گام بردارد.
درادامه این جلسه، همچنین شرکتهای حوزه سلولهای بنیادی و پزشکی بازساختی با معرفی محصولات خود به بیان ظرفیتهای خود در حیطه صادرات محصولات تولیدی دراین حوزه به کشورهای مورد نظر پرداختند.
براساس این گزارش، سفرای هر کشور نیز با بیان شرایط صادرات محصولات سلولهای بنیادی و پزشکی بازساختی به کشورهای هدف، به بحث و تبادل نظر در این زمینه پرداختند.
این درحالی است که ستاد توسعه علوم و فناوریهای سلولهای بنیادی معاونت علمی با هدف توسعه علوم و فناوریهای سلولهای بنیادی و پزشکی بازساختی شروع به فعالیت کرده و سعی دارد تا با شناسایی نخبگان فعال در این حوزه از علوم، ظرفیتهای موجود در حوزه آموزش و تحقیقات، تربیت منابع انسانی، ارائه خدمات بالینی و توسعه شرکتهای مستعد درجهت گسترش زیست بوم فناوری گام بردارد.
انتهای پیام/
- هدایای تبلیغاتی
- غذای شرکتی
- تور استانبول
- غذای سازمانی
- خرید کارت پستال
- لوازم یدکی تویوتا قطعات تویوتا
- مشاوره حقوقی
- تبلیغات در گوگل
- بهترین کارگزاری بورس
- ثبت نام آمارکتس
- سایت رسمی خرید فالوور اینستاگرام همراه با تحویل سریع
- یخچال فریزر اسنوا
- گاوصندوق خانگی
- تاریخچه پلاک بیمه دات کام
- ملودی 98
- خرید سرور اختصاصی ایران
- بلیط قطار مشهد
- رزرو بلیط هواپیما
- ال بانک
- آهنگ جدید
- بهترین جراح بینی ترمیمی در تهران
- اهنگ جدید
- خرید قهوه
- اخبار بورس
























